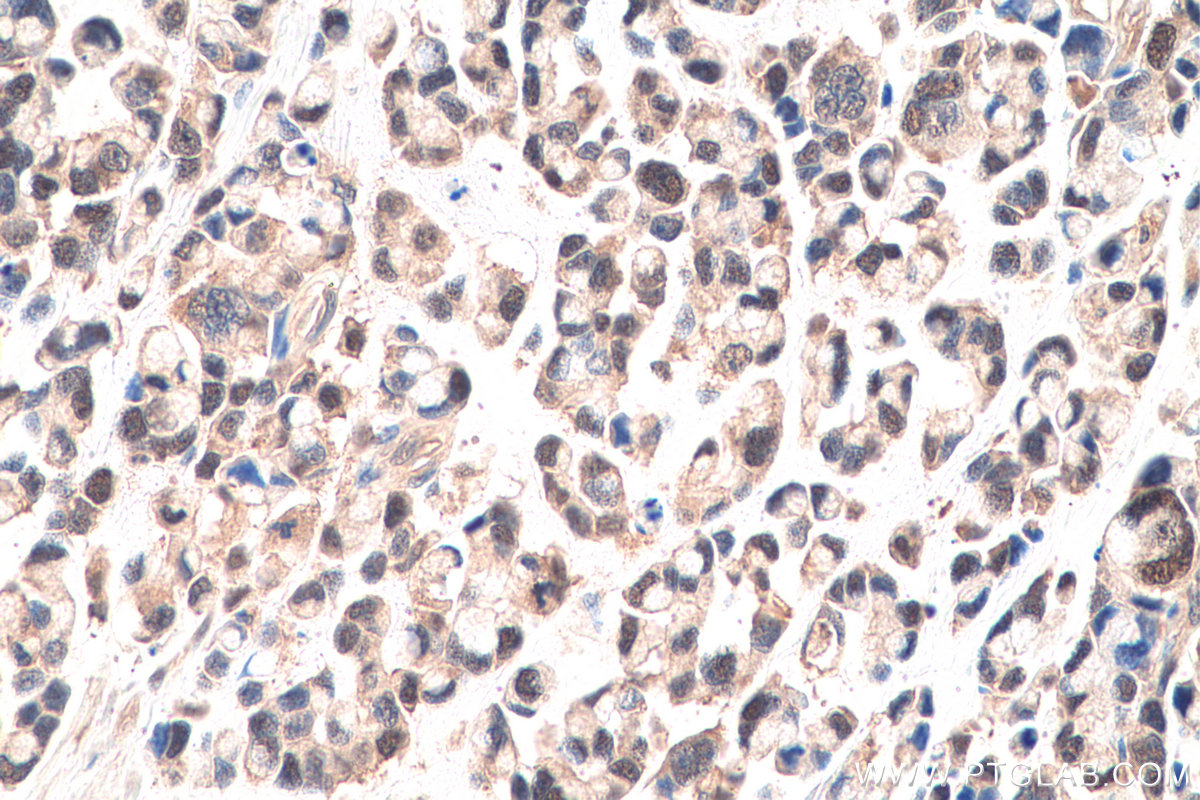

IHCeasy® SURVIVIN Ready-To-Use IHC Kit
SURVIVIN Ready-to-use reagent kit for IHC.
Reactivity
Human, Mouse, Rat
Sample Type
FFPE tissue
Cat no : KHC0646
Synonyms
API4, Apoptosis inhibitor 4, Apoptosis inhibitor survivin, BIRC5, EPR 1, IAP4, SURVIVIN
Validation Data Gallery
Product Information
KHC0646 is a ready-to-use IHC kit for staining of SURVIVIN. The kit provides all reagents, from antigen retrieval to cover slip mounting, that require little to no diluting or handling prior to use. Simply apply the reagents to your sample slide according to the protocol and you're steps away from obtaining high-quality IHC data.
| Product name | IHCeasy SURVIVIN Ready-To-Use IHC Kit |
| Sample type | FFPE tissue |
| Assay type | Immunohistochemistry |
| Primary antibody type | Rabbit Polyclonal |
| Secondary antibody type | Polymer-HRP-Goat anti-Rabbit |
| Reactivity | Human, Mouse, Rat |
Kit components
| Component | Size | Concentration |
|---|---|---|
| Antigen Retrieval Buffer | 100 mL | 50× |
| Washing Buffer | 100 mL ×2 | 20× |
| Blocking Buffer | 5 mL | RTU |
| Primary Antibody | 5 mL | RTU |
| Secondary Antibody | 5 mL | RTU |
| Chromogen Component A | 0.2 mL | RTU |
| Chromogen Component B | 4 mL | RTU |
| Signal Enhancer | 5 mL | RTU |
| Counter Staining Reagent | 5 mL | RTU |
| Mounting Media | 5 mL | RTU |
| Datasheet | 1 Copy | |
| Manual | 1 Copy |
Background Information
Survivin, also called BIRC5, is a unique member of the inhibitor of apoptosis (IAP) protein family. Survivin is a anti-apoptotic protein highly expressed during fetal development and cancer cell malignancy, but is completely absent in terminally differentiated cells. The differential expression of survivin in cancer versus normal tissues makes it a useful tool in cancer diagnosis and a promising therapeutic target. Survivin expression is also highly regulated by the cell cycle and is only expressed in the G2-M phase. It is known that survivin localizes to the mitotic spindle by interaction with tubulin during mitosis and may play a contributing role in regulating mitosis. Disruption of survivin-microtubule interactions results in loss of survivin's anti-apoptosis function and increased caspase-3 activity, a mechanism involved in cell death, during mitosis. It also is a direct target gene of the Wnt pathway and is upregulated by beta-catenin.
Properties
| Storage Instructions | All the reagents are stored at 2-8°C. The kit is stable for 6 months from the date of receipt. |
| Synonyms | API4, Apoptosis inhibitor 4, Apoptosis inhibitor survivin, BIRC5, EPR 1, IAP4, SURVIVIN |